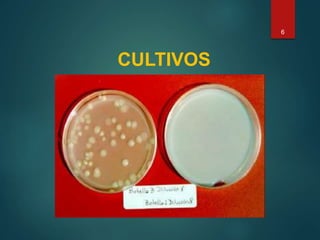
CULTIVOS
6

Este documento describe diferentes organismos utilizados en biorremediación, incluyendo varias bacterias (como Pseudomonas, Bacillus, Rhodococcus), cianobacterias, hongos y algas. Explica las características y usos de bacterias fotosintéticas, nitrificantes, reductoras de azufre, fijadoras de nitrógeno y otras. También menciona arqueas metanógenas y algunas bacterias utilizadas comúnmente en Ecuador para biorremediación.